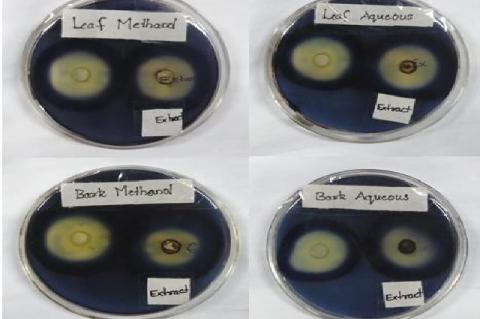
Inhibitory effect of leaf and bark extracts on amylase enzyme.
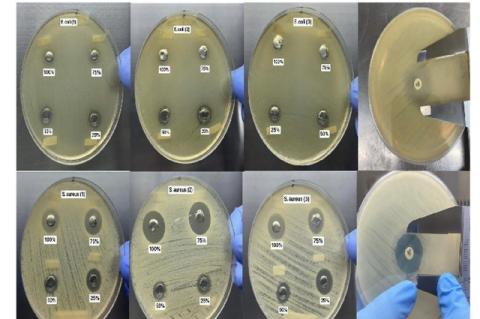
The results of the Agar Well Diffusion Test that shows the Zone of Inhibition of S. aureus and E. coli against the Different Concentrations of the green synthesized CuONPs and control.

Asian Journal of Biological and Life sciences, Vol 13, Issue 2, May-Aug, 2024
Recent Articles
Review Article
A Systematic Review on Biochemical and Pharmacological Properties of the Active Phytochemicals Present in Aegle marmelos (L).
Mrudhulla Sivakumar,Pariyaporn Itsaranuwat,Narendhirakannan RT
Asian J. Biol. Life Sci.,13(2):250-257 DOI: 10.5530/ajbls.2024.13.32 Published: Tue, 24-Sep-2024 Read More
Review Article
Orchid Mimicry: Insight into a Fascinating Floral Phenomenon
Shivani Kondal,L.K. Attri
Asian J. Biol. Life Sci.,13(2):258-265 DOI: 10.5530/ajbls.2024.13.33 Published: Sat, 21-Sep-2024 Read More
Research Article
A Critical Review on Sleshaka Kapha of Ayurveda and its Affiliates in Physiological Perspective
MulaRam Suthar, ,Rakesh Roushan
Asian J. Biol. Life Sci.,13(2):266-270 DOI: 10.5530/ajbls.2024.13.34 Published: Sat, 21-Sep-2024 Read More
Review Article
The Chemical Constituents and Diverse Pharmacological Importance of Simarouba glauca DC.
Mariya Angel Auga Jeyasingh,Venkatesh Rajendran
Asian J. Biol. Life Sci.,13(2):271-277 DOI: 10.5530/ajbls.2024.13.35 Published: Sun, 22-Sep-2024 Read More
Review Article
Mycorrhizal Associations in Orchids: A Review
Paras Chauhan,L.K. Attri
Asian J. Biol. Life Sci.,13(2):278-286 DOI: 10.5530/ajbls.2024.13.36 Published: Sun, 22-Sep-2024 Read More
Review Article
The Growth Performance of Spirulina platensis on Media Supplemented with Digested Poultry Droppings Slurry of Biogas Plant
Jeyanthi Kumari Venkatasamy,Radhika Duraisamy,Veerabahu Chockalingam
Asian J. Biol. Life Sci.,13(2):287-296 DOI: 10.5530/ajbls.2024.13.37 Published: Sun, 22-Sep-2024 Read More
Research Article
Seasonal Dynamics and Ecological Health of Ullal Lake in Bengaluru North, Karnataka, India Introspected through Limnological Perspective and Physiological Response Assessment on Zebrafish (Danio rerio)
Mathews Payoor Raj,Reena Susan Philip
Asian J. Biol. Life Sci.,13(2):297-307 DOI: 10.5530/ajbls.2024.13.38 Published: Sun, 22-Sep-2024 Read More
Research Article
Analysis of Trace and Macroelements of Lepidocephalichthys berdmorei in Relation to Sex and Seasonal Variation
Ningombam Pratima,Wangkheimayum Vidyarani Devi
Asian J. Biol. Life Sci.,13(2):308-315 DOI: 10.5530/ajbls.2024.13.39 Published: Sun, 22-Sep-2024 Read More
Research Article
Studies on in vitro Anti-Diabetic Activities of the Epigeic Earthworm, Eisenia fetida Extract
Aishwarya Shetty,Pulikeshi M. Biradar
Asian J. Biol. Life Sci.,13(2):316-321 DOI: 10.5530/ajbls.2024.13.40 Published: Sun, 22-Sep-2024 Read More
Research Article
Antidiabetic and Antimicrobial Properties of Leaf and Bark Extracts of Cerbera odollam
Sonia Angeline Martin,Esther Shoba,Suchithra Jayakumar,Muhammed Asharudheen
Asian J. Biol. Life Sci.,13(2):322-329 DOI: 10.5530/ajbls.2024.13.41 Published: Sun, 22-Sep-2024 Read More
Research Article
Antibacterial Activity of Green Synthesized Copper Oxide Nanoparticles Using Muntingia calabura Leaf Extracts against Staphylococcus aureus and Escherichia coli
Sistine Zen S. Alvarez,Karrie R. Abraham,Ryana Daniele T. Azurin,Isaac Gabriel O. Bacani,Isaac Gabriel O. Bacani,Andre Manuel G. Bato,Kimberly Anne L. Budomo,Pamela Rose Bremner
Asian J. Biol. Life Sci.,13(2):330-337 DOI: 10.5530/ajbls.2024.13.42 Published: Sun, 22-Sep-2024 Read More
Research Article
In vivo Antibacterial Activity of Biosynthesized Selenium Nanoparticles using a Zebrafish Model
Christa Judiel Ram Amor,Ronee Anne Angal Abaya,Charo Mikaella A. Alcera,Bien Jaric Vald Antonio,Tatum Ranile Bautista,Princes Mae Oborsa Baximen,Gabrielle Frances Cr Berido,Joshua Carl Lim Boe,Pamela Rose Flore Bremner, ,
Asian J. Biol. Life Sci.,13(2):338-346 DOI: 10.5530/ajbls.2024.13.43 Published: Sun, 22-Sep-2024 Read More
Research Article
Plant Growth Promotion in Solanum lycopersicum through Endophytic bacteria Isolated from Flower of Samanea saman
R. Marivignesh,M. I.Zahir Hussain,P. Chithaiya,Sithi Jameela,M. Vijayalakshmi
Asian J. Biol. Life Sci.,13(2):347-352 DOI: 10.5530/ajbls.2024.13.44 Published: Sun, 22-Sep-2024 Read MoreHematological and Systemic Toxicity of in ovo Flubendiamide Exposure in Newly Hatched Domestic Chicks
Dhanush Danes,Juhi Vaishnav,Suresh Balakrishnan
Asian J. Biol. Life Sci.,13(2):353-359 DOI: 10.5530/ajbls.2024.13.45 Published: Sun, 22-Sep-2024 Read More
Research Article
Exploring its Repellent and Histopathological Efficacy of Tinospora cordifolia against Vector Borne Mosquitoes
Antony Annammal,P. Preethi,B. Geetha
Asian J. Biol. Life Sci.,13(2):360-367 DOI: 10.5530/ajbls.2024.13.46 Published: Fri, 27-Sep-2024 Read More
Research Article
Investigating the Anti-Biofilm Ability of Synergistic Drug Coated Urinary Catheters: In vitro Study
Naveena Rajasree R,Thangavel M
Asian J. Biol. Life Sci.,13(2):368-375 DOI: 10.5530/ajbls.2024.13.47 Published: Sun, 22-Sep-2024 Read More
Research Article
Effect of Dissolved Oxygen on Infectivity Pattern of Cestodes Lytocestus haryanii in Fish Clarias batrachus L. of River Yamuna, Yamuna Nagar (Haryana), India
Sushil Kumar Upadhyay, ,Manoj Singh,Nirmala Sehrawat,Raj Singh,Yogendra Prasad Pandey,Nisha Vashishta
Asian J. Biol. Life Sci.,13(2):376-383 DOI: 10.5530/ajbls.2024.13.48 Published: Sun, 22-Sep-2024 Read More
Research Article
Density, Abundance and Diversity of Insect Pollinators at Agro-Ecosystems of Kodagu District, Karnataka, India
Nalini Ballachand Monappa,Basavarajappa Sekarappa
Asian J. Biol. Life Sci.,13(2):384-394 DOI: 10.5530/ajbls.2024.13.49 Published: Sun, 22-Sep-2024 Read More
Research Article
Foraging Niche and Food Preference of Selected Insectivorous Birds from Family Monarchidae and Muscicapidae (Passeriformes) in Girnar Wildlife Sanctuary, Gujarat, India
Usha J. Zala,Jatin V. Raval
Asian J. Biol. Life Sci.,13(2):395-402 DOI: 10.5530/ajbls.2024.13.50 Published: Sun, 22-Sep-2024 Read More
Research Article
Efficacy of Protocol Based Integrated Management of Chronic Sports Injuries W.S.R to Elbow Joint: A Randomised Controlled Trial
Harishankar P. V,Ramesh S. Killedar,Deepti Bagewadi,Pradeep S. Shindhe
Asian J. Biol. Life Sci.,13(2):403-413 DOI: 10.5530/ajbls.2024.13.51 Published: Sun, 22-Sep-2024 Read More
Research Article
Optimizing Cultivation Techniques and Nutritional Profiles of Selected Brinjal Varieties in Solana
Nizarudeen Soumyamol,Muhammed Jameelabhe Sheeba
Asian J. Biol. Life Sci.,13(2):414-420 DOI: 10.5530/ajbls.2024.13.52 Published: Sun, 22-Sep-2024 Read More
Research Article
Studies on Ethno-Veterinary Plant Species of Rajaji National Park and Adjoining Areas
Bharti Singh,Saraswati Nandan Ojha,Maneesha Singh
Asian J. Biol. Life Sci.,13(2):421-431 DOI: 10.5530/ajbls.2024.13.53 Published: Sun, 22-Sep-2024 Read More
Research Article
Heat Stress-Induced Changes in Growth and Essential Oil Profile of German Chamomile (Matricaria chamomilla)
,Kamla Dhyani Jakhmola,Suman Khanduri,Girish Chandra
Asian J. Biol. Life Sci.,13(2):432-438 DOI: 10.5530/ajbls.2024.13.54 Published: Sun, 22-Sep-2024 Read More
Research Article
Optimization of Nutrient and Physical Parameters for the Enhanced Dibenzothiophene Desulfurization Activity by Streptomyces sp. VUR PPR 102
Praveen Reddy,Umamaheswara Rao
Asian J. Biol. Life Sci.,13(2):439-447 DOI: 10.5530/ajbls.2024.13.55 Published: Sun, 22-Sep-2024 Read More
Research Article